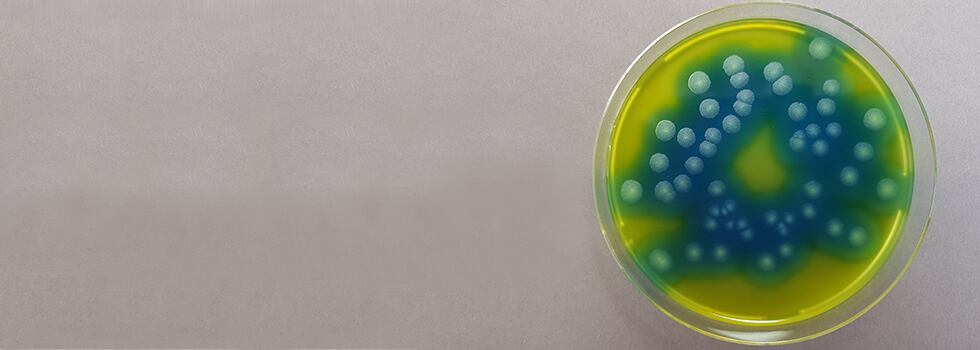

Launch of GranuCult PEMBA (Polymyxin pyruvate egg yolk mannitol bromothymol blue agar) acc. ISO 21871
Bacillus cereus infection is a significant risk with dairy products, thanks to the bacteria’s natural pervasiveness and ability to survive pasteurization. Merck is a leading provider of ISO compliant culture media for food and water analyses with a full documentation of the products that helps customers in audits and lab inspections.
Part of our compliance initiative is the closure of some gaps in our ISO-relevant dehydrated culture media portfolio. One gap we identified is in our culture media range to serve especially dairy customers with products to work according to “ISO 21871: Microbiology of food and animal feeding stuffs — Horizontal method for the determination of low numbers of presumptive Bacillus cereus — Most probable number technique and detection method”. This standard describes the usage of both PEMBA and MYP agars for testing of products intended for human consumption, the feeding of animals, and environmental samples in the area of food production and food handling.
The usage of PEMBA can shorten the time to results by one day because the confirmation procedures of presumptive positive B. cereus colonies using the two agars are different. Presumptive colonies on MYP agar need to be subcultured on sheep blood agar for a hemolysis test. This requires an additional 24 hours and an additional agar plate. Using PEMBA, suspect colonies can be directly microscopically analysed without the need for subcultivation by staining of spores using Malachite Green and by staining of intracellular fat using Sudan Black B. Appearance of Bacillus cereus under the microscope is very typical as brick-shaped cells arranged in chains 4 - 5 μm long and 1 – 1.5 μm wide. They contain quite large amounts of intracellular fat which is stained black while the spores appear green. The PEMBA procedure not only saves precious time, it is also the method of choice if access to fresh sheep blood agar plates is difficult.
Fig. 1: Procedure for Bacillus cereus testing in food and animal feeding stuffs (Most Probable Number) according to ISO 21871:2006.

Merck has launched GranuCult PEMBA (Polymyxin Pyruvate Egg yolk Mannitol Bromothymol blue
Agar) acc. ISO 21871 to complete the range of media available to work according to this standard and to bring you accurate results, faster.

As a worldwide leading provider of a broad range of dehydrated granulated and ready-to-use culture media for food, beverages and water microbiology, Merck closely tracks and supports the development of relevant standards aimed at increasing consumer confidence and safety.
Merck's GranuCult granulated media, Readybag pre-weighed granulated media in ready-to-use bags, ReadyPlate and ReadyTube ready-to-use media are all compliant with EN ISO 11133:2014. All information regarding compliance with additional reference standards are displayed on the product label and in the product’s technical information available on
our website.